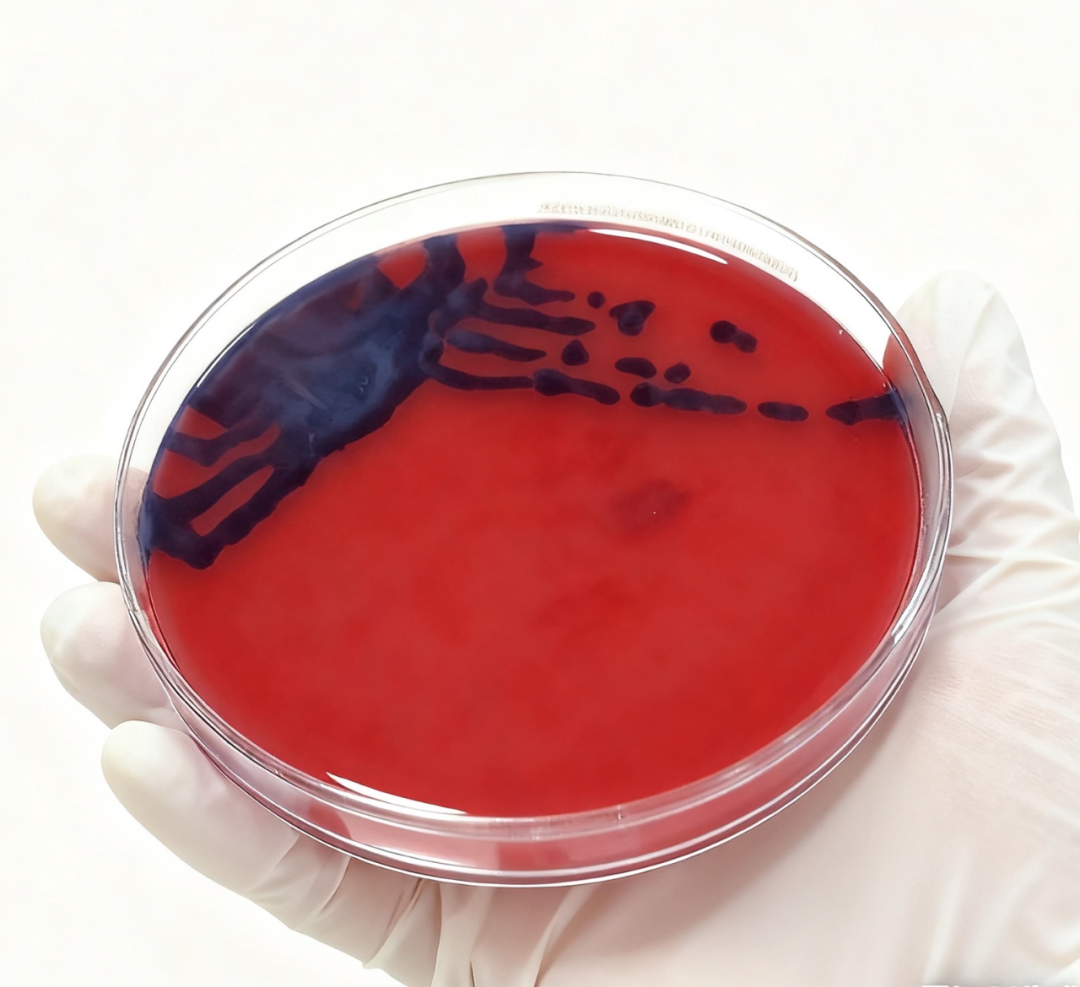

大众卫生报·新湖南客户端11月26日讯(通讯员 邬靖敏 肖丹)近日,长沙市第一医院(中南大学湘雅医学院附属长沙医院)儿科收治了一名8岁男孩小宇(化名)。小宇在田间玩耍时被不明昆虫叮咬小腿,几天后伤口出现异常紫色变化、化脓并伴有发烧。经医院医生详细检查及脓液、分泌物培养等实验室检测,确诊为由一种名为“紫色色杆菌”的罕见细菌引起的感染。经过及时有效的治疗,小宇目前已无发热,感染已控制,伤口基本恢复。
这起罕见的病例为我们敲响了警钟。今天,就带大家了解一下这个隐蔽的“田间杀手”。
什么是紫色色杆菌?
紫色色杆菌是一种较少见的革兰氏阴性杆菌,广泛存在于热带和亚热带地区的土壤和水体中,尤其是静止的、富含有机质的淡水环境(如稻田、池塘、沼泽)。它有一个非常独特的特征,能产生一种紫色色素(即紫色杆菌素),这也是它名称的由来和感染后伤口变紫的原因。
紫色色杆菌(血平板培养的紫色色杆菌,可见其产生的紫色色素)
它是如何感染人体的?
紫色色杆菌通常不会通过人与人之间传播。它的主要感染途径是:
1.皮肤伤口接触:像小宇这样,昆虫叮咬造成的皮肤伤口,或是皮肤本身就有破损,接触了被细菌污染的土壤或水,极大可能将皮肤表面的细菌带入体内。
2.吸入或误食:极为罕见,主要通过呼吸道或胃肠道吸入/摄入被污染的水源。
感染后有哪些症状?
初期症状可能与其他常见细菌感染相似,容易误诊:
1.局部症状:叮咬或受伤处出现脓肿、溃疡,并可能呈现出独特的紫褐色或黑色。这是最具特征性的表现之一。
2.全身症状:随后可能出现高烧、寒战、全身乏力、恶心呕吐等类似流感的症状。
3.严重并发症:若未及时治疗,细菌可能通过血液播散至全身,引起败血症、肝脓肿、肺炎等严重甚至致命的并发症。儿童和免疫力低下者是高危人群。

如何预防与治疗?
1.治疗:紫色色杆菌对许多常用抗生素(如青霉素、头孢一代)天然耐药。一旦怀疑或确诊,必须立即就医,并进行药敏试验,由医生选择有效的抗生素(如环丙沙星、哌拉西林/他唑巴坦、碳青霉烯类等)进行足疗程治疗,严重者需手术清创。
2.预防(关键):暑假是孩子们户外活动的高峰期,预防至关重要:
穿戴防护:在田间、草丛、水塘边玩耍时,尽量给孩子穿着长袖衣裤、长袜和不露脚趾的鞋子,减少皮肤暴露。
使用驱虫剂:喷涂有效的驱蚊驱虫液,防止蚊虫叮咬。
及时清洁:户外活动后,立即用肥皂和清水彻底清洗身体和手脚,特别是任何轻微的划伤或叮咬处。
妥善处理伤口:对任何皮肤破损,无论多小,都要用碘伏进行消毒,并保持清洁干燥。切勿用泥土或不洁的水源冲洗伤口。
提高警惕:如果伤口出现异常疼痛、快速扩散、颜色改变(如发紫)或伴有发烧等症状,务必第一时间到医院就诊,并告知医生详细的户外接触史。
专家提醒
医院儿科及检验科专家提醒各位家长:紫色色杆菌感染虽罕见,但起病急、进展快,不容小觑。户外活动时,“防”大于“治”。做好充分的防护措施,并在出现异常时及时寻求专业医疗帮助,是保护孩子免受其害的关键。
责编:王璐
一审:王璐
二审:梁湘茂
三审:谢峰
湖南日报新媒体
